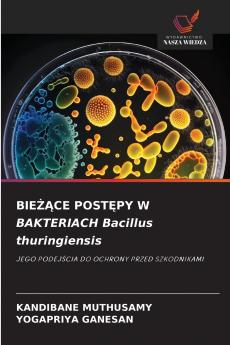
BIEŻĄCE POSTĘPY W BAKTERIACH Bacillus thuringiensis
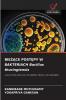
BIEŻĄCE POSTĘPY W BAKTERIACH Bacillus thuringiensis

Polish
Paperback
₹5774
₹7606
24.09% OFF
(All inclusive*)
Delivery Options
Please enter pincode to check delivery time.
*COD & Shipping Charges may apply on certain items.
Review final details at checkout.
Looking to place a bulk order? SUBMIT DETAILS
Delivery Options
Please enter pincode to check delivery time.
*COD & Shipping Charges may apply on certain items.
Review final details at checkout.
About The Book
Description
Author(s)
Bacillus thuringiensis (B.t.) to gram-dodatnia bakteria glebowa stosowana jako jeden z entomopatogenów do zwalczania szkodników z rzędu Lepidoptera w uprawach polowych i ogrodniczych. Różne formuły B.t. były z powodzeniem stosowane do ochrony środowiska i żywności przed skażeniem pozostałościami chemicznych pestycydów w zwalczaniu szkodników. Odkrycie toksyn B.t. o nowej aktywności owadobójczej przeciwko szkodnikom i rozwój genetycznie zmodyfikowanych roślin otworzyły nową erę ochrony przed szkodnikami. Transgeniczne rośliny B.t. w tym kukurydza bawełna i soja zostały już wyprodukowane i skomercjalizowane w celu ochrony upraw przed około 30 głównymi szkodnikami z rzędu Coleoptera i Lepidoptera przynosząc znaczne korzyści środowisku i gospodarce. Jednak wraz z długotrwałą uprawą roślin B.t. niektóre docelowe szkodniki stopniowo rozwinęły odporność. Liczne badania wykazały że mutacje w genach aktywacji toksyn wiązania toksyn i immunizacji owadów są ważnymi źródłami odporności na szkodniki. Dogłębne zbadanie odpowiednich mechanizmów odporności B.t. pomoże w opracowaniu nowych strategii zapobiegania i zwalczania szkodników.
Details
ISBN 13
9786202193528
Publication Date
-13-09-2025
Pages
-96
Weight
-142 grams
Dimensions
-152x229x5.84 mm